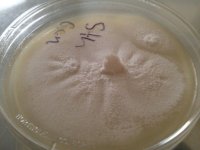
IMG_0332.JPG

smoothmonkey
Rising Star
Greetings fellow humanoids,
I recently started my first Golden Teacher grow. I chose GT's because they seemed the simplest and easiest to grow for a first timer. I just had a few questions for some of you more experienced cultivators:
Do you have a favorite strain of entheogenic (or other type!) of mushroom to grow and why?
Are there any type of mushrooms you dislike growing or wouldn't grow again?
Skill and procedure set aside, I'm interested in what strain is your favorite!
Thanks in advance,
-monkey
I recently started my first Golden Teacher grow. I chose GT's because they seemed the simplest and easiest to grow for a first timer. I just had a few questions for some of you more experienced cultivators:
Do you have a favorite strain of entheogenic (or other type!) of mushroom to grow and why?
Are there any type of mushrooms you dislike growing or wouldn't grow again?
Skill and procedure set aside, I'm interested in what strain is your favorite!

Thanks in advance,
-monkey